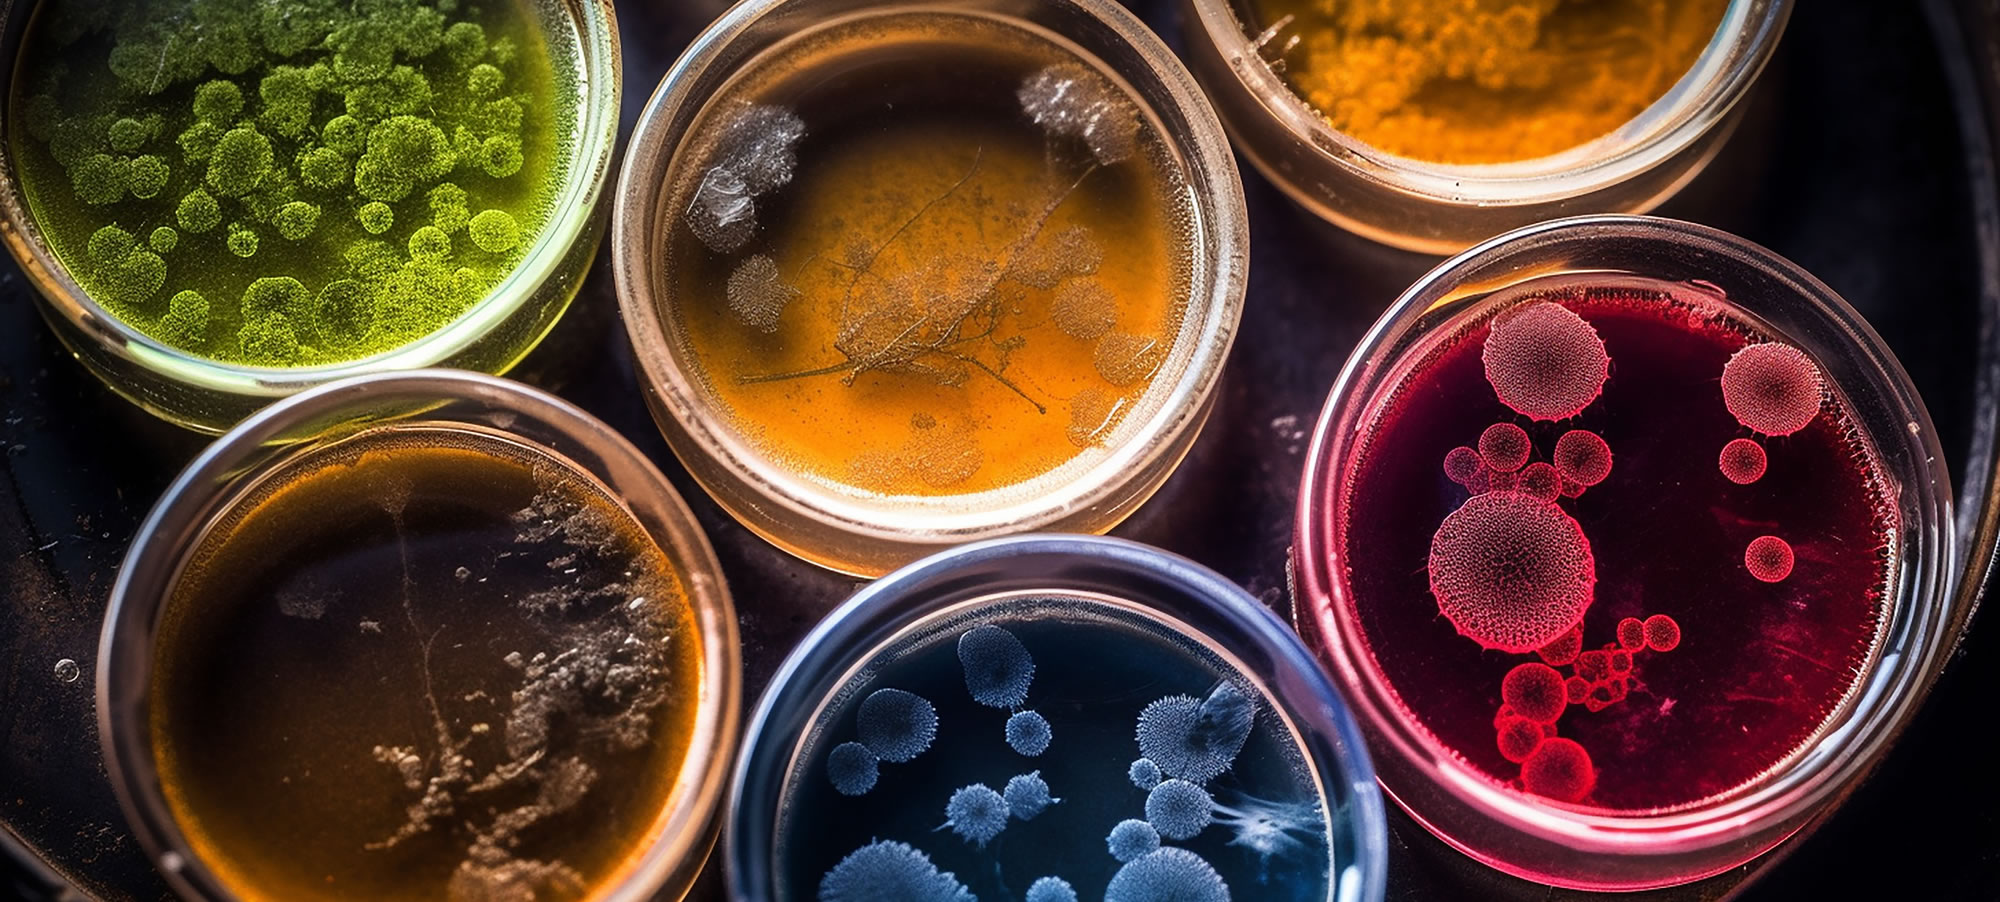

拠点に内包される技術・仕組み・機能等
目的
実生産の培養環境不安定性に頑強な(ロバスト)微生物を設計提案する
背景
- スケールアップで生産性が落ちる・・・
- ある濃度以上にいかない・・・
- 酵素活性が落ちる・・・
- 細胞内の状態がわからない・・・
「代謝・遺伝子発現変動を明確化」
「ボトルネック反応の解除アイデアの提案」
で、産業微生物創製の開発を加速!
情報解析依頼の窓口機能設置
拠点の強みとなる保有技術
01
代謝ダイナミクス予測を用いた改変すべき反応の提案
大腸菌・コリネ型細菌にて実証中。
02
情報解析モデルを用いたバイオ生産性の安定化に向けた候補遺伝子の提案
コリネ型細菌・糸状菌にて実証中。
03
AI代謝予測にもとづく高生産性を担保する培養キー因子・条件の提案
大腸菌・コリネ菌にて実証中。
04
分子シミュレーションおよび配列設計技術による目的酵素の高活性化
保有技術
培養予測モデル
情報解析モデル
AI代謝予測モデル
酵素設計モデル

- 細胞設計の指針
- 技術コンサルティング